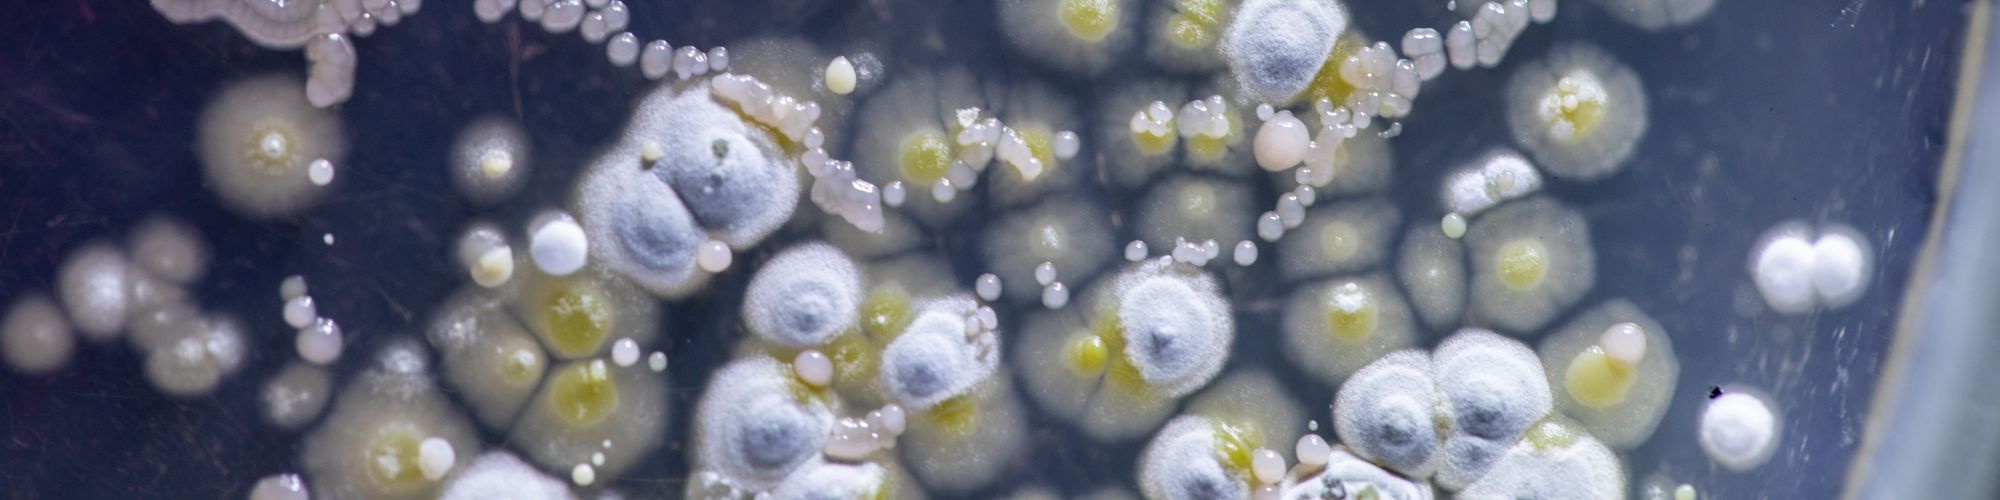
Schimmelpilzkulturen

Schimmelpilze in Innenräumen
Wir helfen Ihnen, die Ursachen für einen Schimmelpilzbefall in Ihren Räumen aufzuklären und sorgen für eine nachhaltige Sanierung!
-
Klärung der Fragestellung
Eingrenzung des jeweiligen Problems durch gezieltes Abfragen von wichtigen Schadensparametern, in der Regel schon bei der ersten telefonischen Kontaktaufnahme. Bei weniger schweren Fällen ist möglicherweise schon diese erste telefonische Kurzberatung ausreichend, um den Betroffenen eine Schadensbehebung zu ermöglichen - diese telefonische Erstberatung führen wir ohne Berechnung durch!
-
Ortsbegehung
Die persönliche Inaugenscheinnahme des Schimmelpilzschadens (soweit optisch erkennbar) sowie eine gezielte Erhebung von schimmelpilzrelevanten Rahmenparametern anhand einer Checkliste vor Ort ist die wesentliche Grundlage für alle weiteren Maßnahmen. Je nach Fragestellung werden - da wo sinnvoll und beurteilungsrelevante Erkenntnisse zu erwarten - ergänzende Untersuchungen angestellt.
- Bauphysikalische Messungen (Luft- und Wand-/Materialfeuchte, Luft- und Oberflächentemperaturen, Langzeitmessungen von Temperatur und Feuchte)
- Entnahme und Untersuchungen von Oberflächen-, Material- und Raumluftproben (Keimbelastung, differenzierende Schimmelpilzauswertung, bei Bedarf auch bakteriologische Untersuchungen)
- Raumluftuntersuchungen auf pilzspezifische flüchtige organische Verbindungen (MVOC) bei Verdacht auf verdeckten Schimmelpilzbefall
-
Untersuchungsbericht
Der Untersuchungsbericht kommt bei uns nicht von der Stange, sondern ist der jeweiligen Fragestellung angepasst. Geht es z.B. "nur" um die Frage, ob überhaupt ein Schimmelpilzbefall vorliegt und kann dieses aufgrund der Untersuchungsergebnisse ausgeschlossen werden, so ist ein knapper und damit kostengünstiger Prüfbericht völlig ausreichend. Liegt jedoch ein relevanter Schimmelpilzbefall vor, so ist eine ausführliche Dokumentation der durchgeführten Untersuchungen und umfassende Darstellung der Beurteilungsgrundlagen sinnvoll. Abgerundet wird ein solcher ausführlicher Untersuchungsbericht durch Handlungsempfehlungen zur weiteren Vorgehensweise. Ist eine Sanierung erforderlich, werden Vorgaben für die konkrete Durchführung formuliert.
-
Sanierung
Bei größeren Schäden sollte die Sanierung möglichst durch kompetente Fachfirmen erfolgen. Bei Bedarf unterstützen wir Sie mit der Erarbeitung eines detaillierten Sanierungskonzeptes und Erstellung von Leistungsverzeichnissen zur Ausschreibung oder Vergabe der Sanierungsleistungen. Während der Sanierungsarbeiten übernehmen wir auf Wunsch die Überwachung einer sach- und termingerechten Durchführung.
-
Erfolgskontrolle
Bei größeren Schadensfällen mit nachfolgender Sanierung sollte - möglichst vor dem Wiederaufbau der betroffenen Bereiche - eine Erfolgskontrolle mittels einer Raumluftmessung auf Schimmelpilze durchgeführt werden. Bewährt hat sich in solchen Fällen eine so genannte Gesamt-Zellzahlmessung (Partikelmessung) mit lichtmikroskopischer Auswertung, da hier die Ergebnisse kurzfristig (z.B. 24-48 h) vorgelegt werden können. Ggf. können weitere Kontrollmessungen in größerem zeitlichen Abstand zur Sanierung sinnvoll sein.